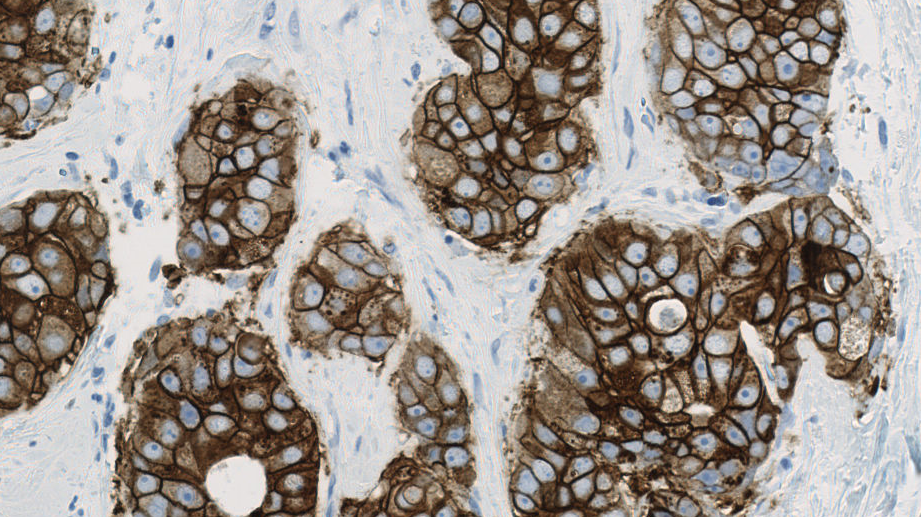

Visiopharm granted patents for stain quality management in tissue biomarkers
Visiopharm®, the Denmark-based leader in artificial intelligence-driven image analysis, tissue mining, and precision pathology, has been granted patents in the US and Europe for an AI and image analysis based approach to quantifying staining quality in tissue sections stained with IHC or ISH based tissue biomarkers.
The use of tissue biomarkers is key to diagnostic treatment decisions, the inclusion of patients in clinical trials, and making critical decisions about entire drug development programs. Yet, staining quality and standardization remains a challenge to the efficient use of tissue biomarkers. External Quality Assurance (EQA) organizations offering proficiency testing programs, such as NordiQC and UK NEQAS, have documented failure rates as high as 30% in diagnostic pathology labs for certain biomarkers.
Through repeated testing and protocol review/recommendations, quality programs play an essential role in managing and improving staining quality, ultimately leading to benefits for patients. Yet EQAs have limitations in terms of the number of runs they can offer per biomarker per year, uniform standards, and the number of labs they can serve.
Quality variations can come from many sources, along the value chain in sample preparation. The frequency in variation of staining quality in a typical pathology lab often exceeds the frequency in EQA proficiency testing, thus creating an unmet need for quality testing.
AI and image analysis for decision support is just one component to improve precision and standardization of biomarker assessment. Managing stain quality and sufficiency are both critical to precision, and issues Visiopharm is addressing as part of our end-to-end quality commitment. We see the technology behind these patents as a first step of the way,
Michael Grunkin PhD, CEO at Visiopharm
“AI and image analysis for decision support is just one component to improve precision and standardization of biomarker assessment. Managing stain quality and sufficiency are both critical to precision, and issues Visiopharm is addressing as part of our end-to-end quality commitment. We see the technology behind these patents as a first step of the way”, said Visiopharm CEO Michael Grunkin, and continued, “later this year we will release a platform that will allow both EQAs and diagnostic pathology labs to leverage the power of AI in proficiency testing and stain quality management. Working closely with UK NEQAS and NordiQC for close to a decade has been instrumental in understanding the requirements for stain quality management tools.”
About Visiopharm A/S
Visiopharm® is a world leader in AI-driven Digital Pathology solutions.
Visiopharm’s pioneering image analysis tools support thousands of scientists, pathologists, and image analysis experts in academic institutions, biopharmaceutical industry, and diagnostic centers. Their AI-based image analysis and tissue mining tools support research and drug development research worldwide, while CE-IVD APPs support primary diagnostics. With the most advanced and sophisticated artificial intelligence and deep learning, Visiopharm delivers tissue data mining tools, precision results, and workflows.
Visiopharm was founded in 2001 and is privately owned. The company operates internationally with over 900 licenses and countless users in more than 40 countries. The company headquarters are in Denmark’s Medicon Valley, with offices in Sweden, England, Germany, and the United States.



